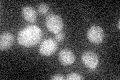
YOL027C

View description
Mitochondrial inner membrane protein, involved in membrane integration of a subset of mitochondrial proteins; required for K+/H+ exchange; associates with mitochondrial ribosomes; human ortholog Letm1 implicated in Wolf-Hirschhorn syndrome
Localization:
Intensity:
Fold change:
Significance:
-
C’ GFP library in SD
below threshold17.29 -
N' NOP1pr-GFP in SD

mitochondria117.238 -
N' TEF2pr-mCherry in SD

missing0 -
N' NATIVEpr-GFP in SD

mitochondria48.5826 -
N' TEF2pr-VC and Cyto-VN in SD

#N/A0 -
C’ GFP library in SD+DTT

cytosol18.361.06No -
C’ GFP library in SD+H2O2

cytosol17.681.02No -
C’ GFP library in Starvation Media

cytosol14.740.85No -
C’ GFP library on the background of Pup2-DaMP

below threshold -
C’ GFP library on the background of CCT mutant

below threshold18.8331.08865No
